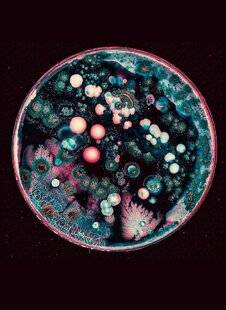
Science & Vie 1299 De quelles couleurs sont les micro-organismes ?

Êtes-vous sûr de vouloir effectuer cette action ?
Science & Vie - Le numéro 1299 du 21 novembre 2025
Consultez le sommaire détaillé des articles parus dans ce numéro de Science & Vie.
Feuilletez un extrait de cette parution. Achetez le numéro au format papier ou numérique pour le retrouver sur votre espace client et l’application KiosqueMag.
KiosqueMag, la boutique officielle de Science & Vie propose l’accès le plus complet aux archives de la revue.

Au sommaire de ce numéro

UNE MÊME ESPÈCE PEUT-ELLE AVOIR DES PHÉNOTYPES SI DIFFÉRENTS ?

RETOUR SUR LA FÊTE DE LA SCIENCE

Quelle est la forme d'un trou noir ?

Développer les prêts à contrepartie écologique

ON A DÉCOUVERT UNE CROIX D'EINSTEIN À CINQ POINTS